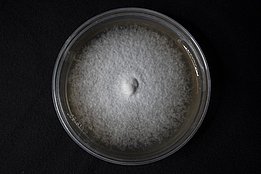

07.01.2025 | Haoyun Liu | WSL News
By chance, two Zurich-based artists have discovered the bioluminescence of a mushroom. Together with a mycologist from the Swiss Federal Institute for Forest, Snow and Landscape Research WSL, they describe the poorly understood phenomenon.

Glowing mushrooms are often associated with tropical environments, but they can also be found in Switzerland. In fact, Zurich-based artists Heidy Baggenstos and Andreas Rudolf have been working with bioluminescent organisms for more than 10 years. “We want to show that these bioluminescent mushrooms are present in Swiss forests and that we do not have to travel far to find them,” explains Baggenstos.
One evening, while walking through the forest in Albisrieden, a neighbourhood in Zurich, the duo observed some green light through their camera. Sometimes the fungi’s bioluminescence is so weak it cannot be seen with the naked eye. “Nowadays we always have our mobile phones or a flashlight, but to see bioluminescence in the forest, it has to be pitch black.”, says Rudolf.
The artists collected some samples of the glowing specimen thinking it was Mycena haematopus, a known bioluminescent species. Back in their well-lit studio, they realised it was another species, Mycena crocata, the saffron drop bonnet mushroom, known for its saffron-coloured milk, which had not previously been described as bioluminescent.

Crossing disciplines ¶
Together with Renate Heinzelmann, a mycologist at the WSL, they further characterised this new discovery. The artists measured the amount of light emitted by different parts of the mushroom using long exposure photographs and a luminometer, which amplifies weaker light more than a camera. "Most of the experiments were conducted by the artists. They collected the samples, took the photographs, and made the light measurements," Heinzelmann acknowledges.
Bioluminescence is a chemical process by which living organisms generate light, and fungi have evolved their own distinct mechanism. The key step is the conversion of luciferin by the enzyme luciferase, into an unstable product, which releases energy in the form of light upon its decay. Unlike fluorescence, this process does not require an external light source.
The light measurements revealed that the fruiting body of M. crocata (see Box), apart from the stipe base, is non-luminous, while the mycelium showed the most bioluminescence. The mycelium is the underground network of a mushroom, analogous to the roots of plants. As a result, the decaying wood M. crocata grows on can also emit a green glow when split open, lasting up to 4 hours, until the wood dries up. When Baggenstos and Rudolf grew pure mycelia cultures, under optimal conditions,these remained bioluminescent for up to 164 days.
Why bioluminesce? ¶
Genetic experiments by Heinzelmann confirmed the species identity, as well as the presence of bioluminescence-related genes found in all glowing fungi of the Mycena genus, the bonnet mushrooms. "There will constantly be more bioluminescent species discovered”, Heinzelmann predicts, “Bioluminescence is under-researched, and the more people look, the more they will find.”
Bioluminescent fungi have been a source of fascination since Aristotle first observed them over two thousand years ago, describing them as a “cold fire” emanating from decaying wood. Yet, the mystery surrounding this phenomenon has persisted over time. Although the biological mechanism is now understood, its ecological function remains uncertain. While some glowing mushrooms might attract insects to disperse spores, the bioluminescence of hidden mycelium does not fit this hypothesis. "It seems that bioluminescence has been maintained for a long time, so we assume it has some function”, says Heinzelmann, “but it’s still a mystery."
Fungi Anatomy 101
Fruiting body (also known as basidiome): is the part of mushrooms we usually think of, which is the spore-producing organ. Not all fungi have a fruiting body.
Spore: a reproductive unit of fungi, with a similar function to that of seeds from plants, but while a seed is made of many cells, a spore is a single cell.
Mycelium: underground network of hyphae (filaments) which absorbs nutrients.
Stipe: the 'trunk' of the fruiting body
Latex: milky fluid the mushroom exudes when damaged
Publication ¶
Contact ¶
Links ¶
Baggenstos & Rudolf Website
Copyright ¶
The Swiss Federal Research Institute WSL provides the artwork for imaging of press articles relating to this media release for free. Transferring and saving the images in image databases and saving of images by third parties is not allowed.
